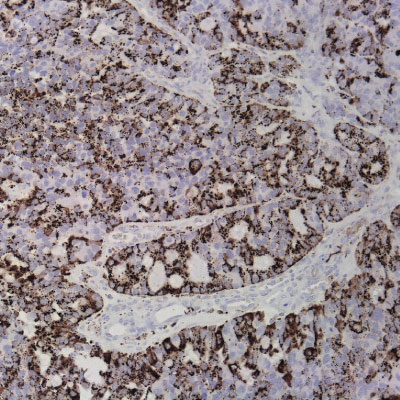
https://vitro.bio/wp-content/uploads/2022/02/Panel-Pleuropulmonar.jpg

Para poder acceder a este sitio web es necesario que preste su consentimiento para que el mismo pueda almacenar o acceder a cookies en su dispositivo. Si desea otorgárnoslo, haga clic en “Aceptar cookies”. Previamente puede obtener una información más detallada en este enlace. Ver nuestra política de cookies
MICROBIOLOGÍASoftware

Immunohistochemistry integrates a set of methodologies that use antibodies as specific reagents capable of identifying and establishing specific links with tissue constituents that function as antigens.
Established bindings can be visualized under microscopic observation, due to the labeling of antibodies that cause color development whenever antigen-antibody complexes are formed.
Vitro Turkey Diagnostics, through its exclusive representation of Master Diagnostica in Turkey, sells antibodies and equipment for immunohistochemical diagnosis (IHC), offering a wide panel of primary antibodies (more than 300 references), as well as universal and high-quality detection systems. sensitivity, based on micropolymer technology for in vitro diagnostics.
With the main objective of providing innovative and top quality antibodies for immunohistochemical diagnosis, we work daily to be informed of the problems and needs of the market, in order to be able to offer our customers the most innovative antibodies with total quality assurance.
- Real time PCR
- Hibridación (DNA Flow)